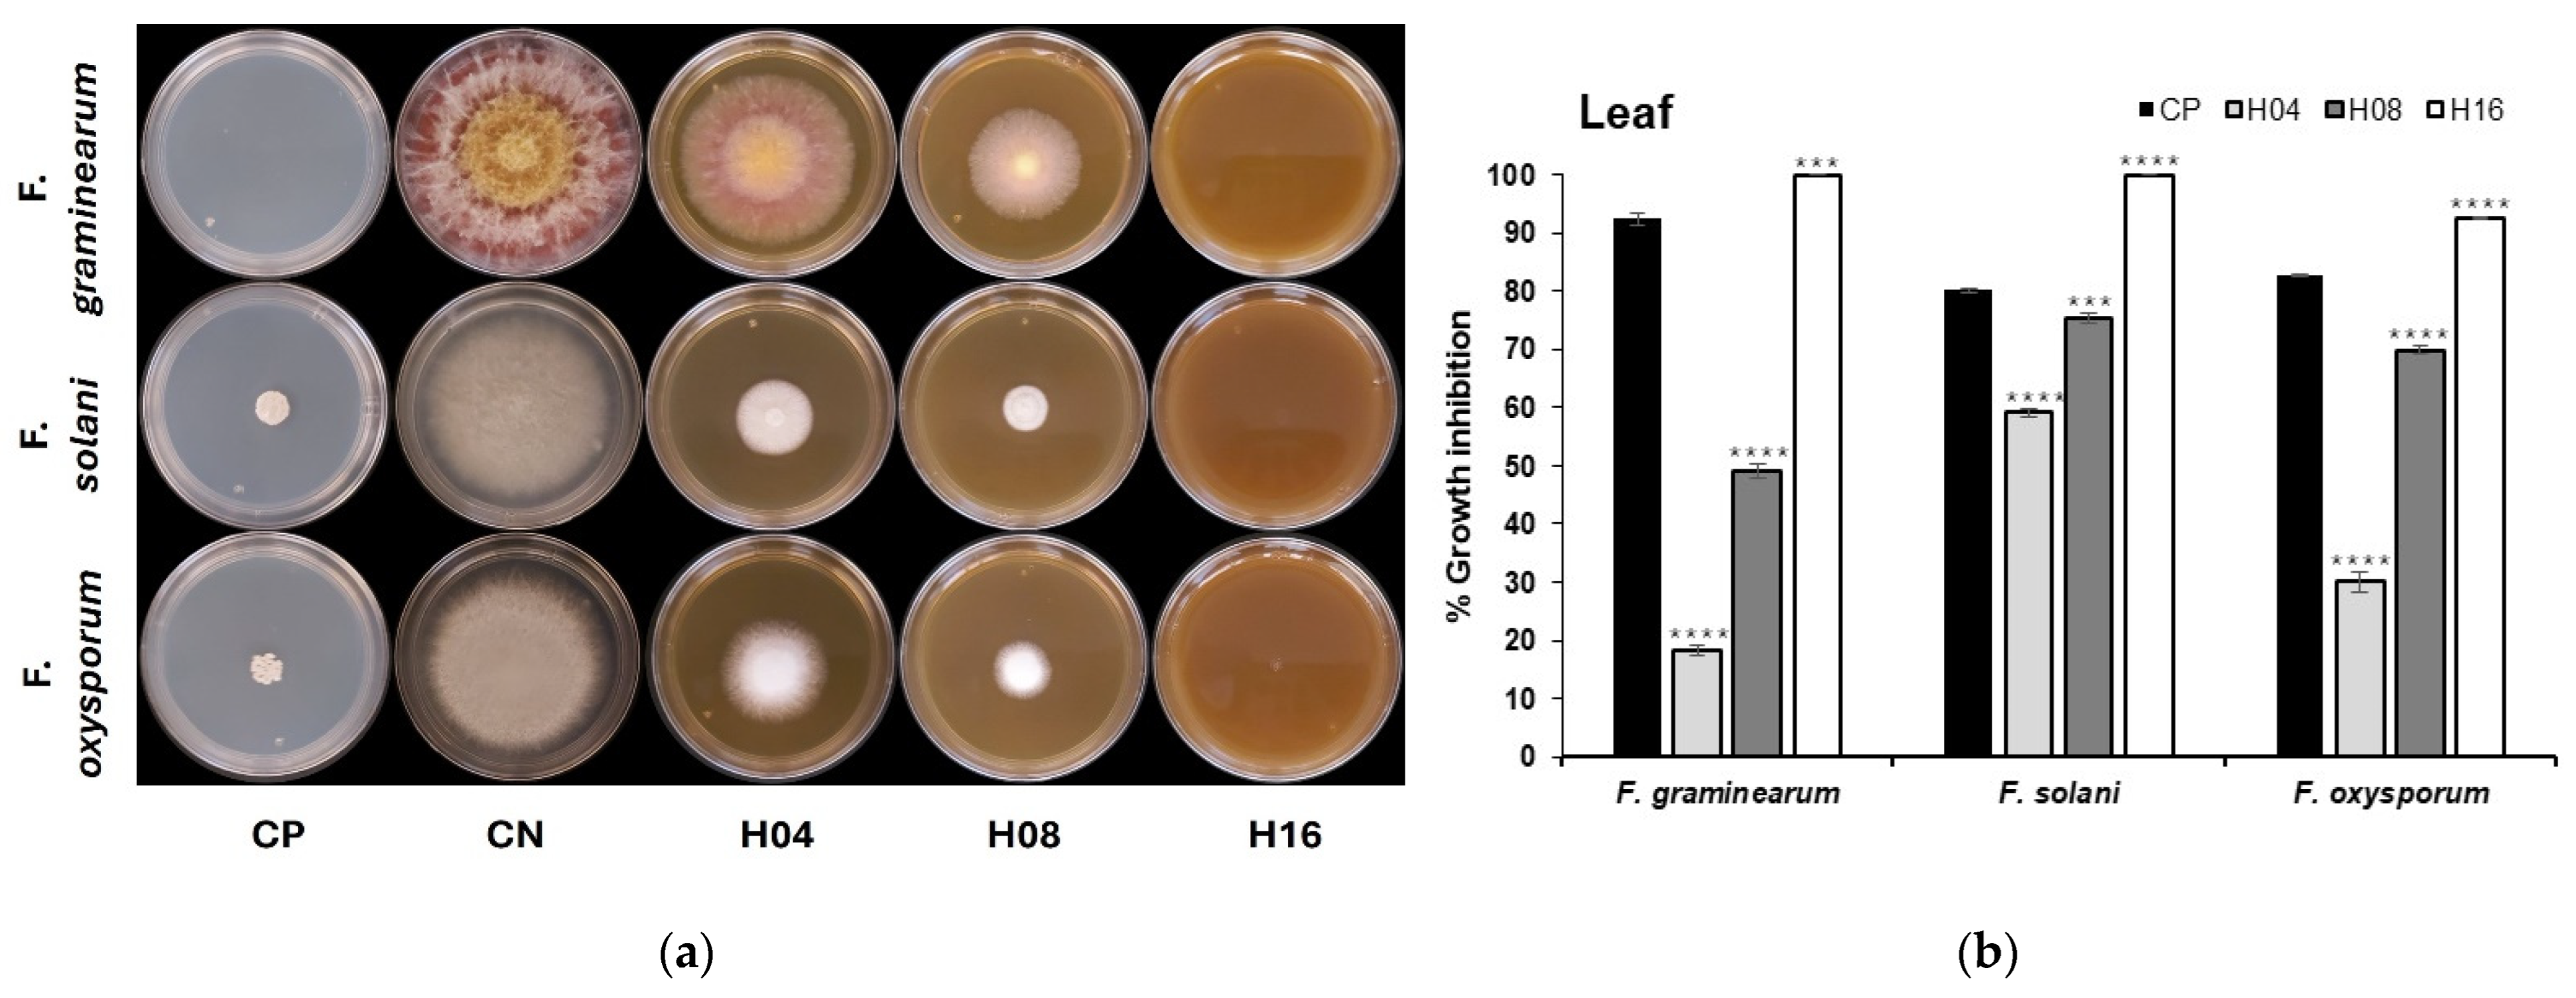
Agriculture 14 01975 g001a
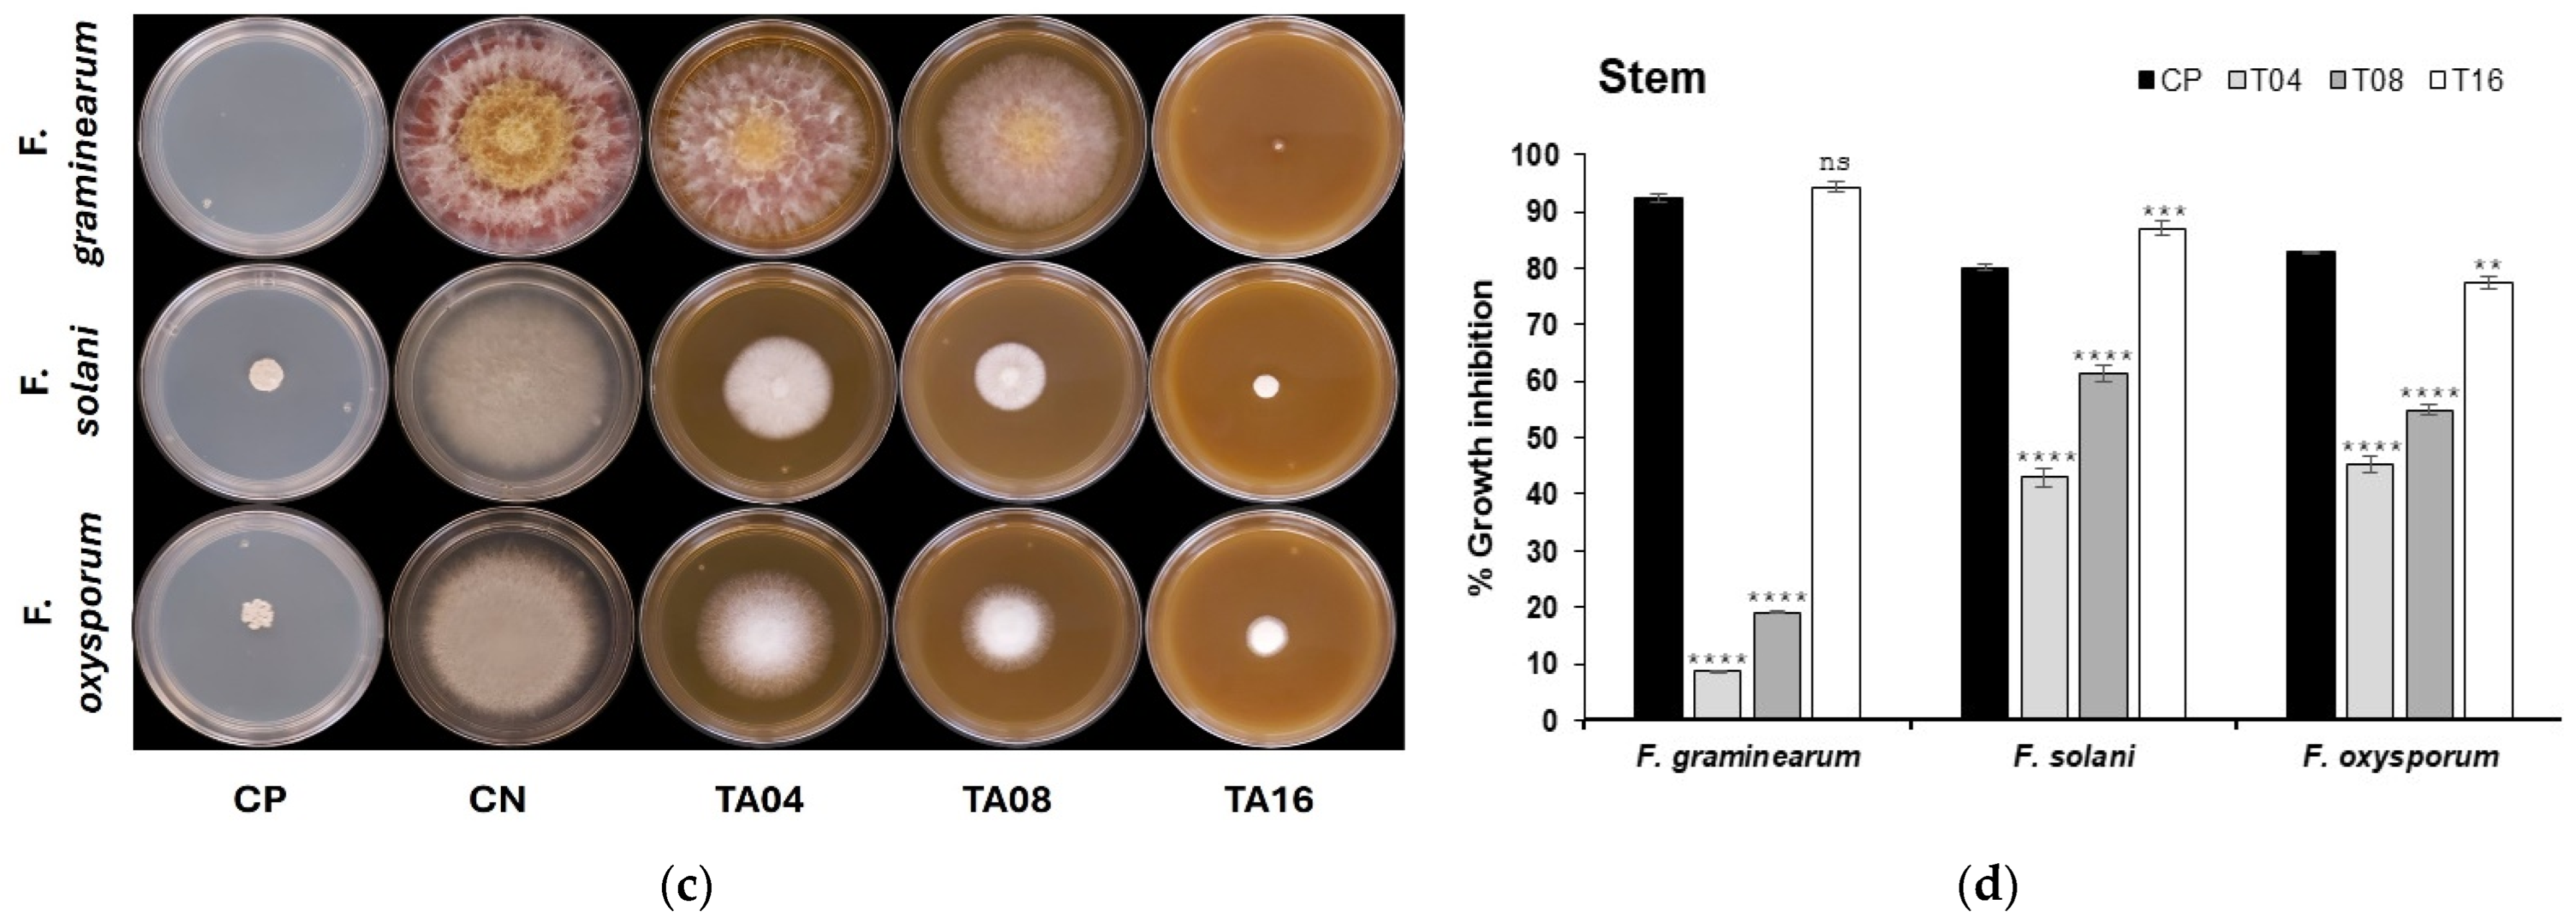
Agriculture 14 01975 g001b

Antifungal Activity of Mexican Oregano (Lippia graveolens Kunth) Extracts from Industrial Waste Residues on Fusarium spp. in Bean Seeds (Phaseolus vulgaris L.)
Abstract
1. Introduction
2. Materials and Methods
2.1. Plant Material and Extraction
2.2. Determination of Chemical Composition by UPLC-MS
2.3. Fungal Strains and Culture Conditions
2.4. In Vitro Antifungal Activity of Oregano Leaf and Stem Residue Extracts on Fusarium spp. Using the Agar Diffusion Method
2.5. In Vivo Evaluation of the Antifungal Activity of Ethanolic Extracts on Fusarium spp. in Common Bean Seeds (Phaseolus vulgaris L.)
2.6. Experimental Design and Statistical Analysis
3. Results
3.1. Yield of Ethanolic Extracts from the Leaf and Stem Residues of Mexican Oregano (Lippia graveolens Kunth)
3.2. Analysis and Determination of the Chemical Composition of the Extracts
3.3. Antifungal Effects of Mexican Oregano (Lippia graveolens Kunth) Extracts Against Phytopathogenic Fungi
3.4. Effects of Mexican Oregano (Lippia graveolens Kunth) Against Phytopathogenic Fungal Infection in Bean (Phaseolus vulgaris L.) Seeds
4. Discussion
5. Conclusions
Author Contributions
Funding
Institutional Review Board Statement
Data Availability Statement
Acknowledgments
Conflicts of Interest
References
- Ma, L.J.; Geiser, D.M.; Proctor, R.H.; Rooney, A.P.; O’Donnell, K.; Trail, F.; Gardier, D.M.; Manners, J.M.; Kazan, K. Fusarium pathogenomics. Annu. Rev. Microbiol. 2013, 67, 399–416. [Google Scholar] [CrossRef]
- Sampaio, A.M.; Araujo, S.D.S.; Rubiales, D.; Vaz Patto, M.C. Fusarium wilt management in legume crops. Agronomy 2020, 10, 1073. [Google Scholar] [CrossRef]
- Benchimol-Reis, L.L.; Bueno, C.J.; Carbonell, S.A.M.; Chiorato, A.F. Patosistema del marchitamiento por Fusarium y el frijol común: Variabilidad de patógenos y control genético. Crop Sci. 2023, 63, 2609–2622. [Google Scholar]
- Islam, S.S.; Adhikary, S.; Mostafa, M.; Hossain, M.M. Vegetable Beans: Comprehensive Insights into Diversity, Production, Nutritional Benefits, Sustainable Cultivation and Future Prospects. OnLine J. Biol. Sci. 2024, 24, 477–494. [Google Scholar] [CrossRef]
- FAO. FAOSTAT. Food and Agriculture Organization. 2024. Available online: http://www.fao.org/faostat/en/#data (accessed on 2 September 2024).
- Siddiq, M.; Uebersax, M.A.; Siddiq, F. Global production, trade, processing and nutritional profile of dry beans and other pulses. In Dry Beans and Pulses: Production, Processing and Nutrition; Wiley: Hoboken, NJ, USA, 2022; pp. 1–28. [Google Scholar] [CrossRef]
- Espinoza, S.S.; Zurita, D.S.; Serna, R.R.; Saucedo, J.C.R. Caracterización genética y productiva de variedades criollas de frijol cultivadas en Durango, México. Agrofaz 2022, 4, 12–19. [Google Scholar]
- Rodríguez, V.Á. Micro y Macrodiversidad: Estudios de Vanguardia en México; Universidad Juárez del Estado de Durango: Durango, Mexico, 2023. [Google Scholar]
- Acosta Gallegos, J.A.; Jiménez Hernández, Y.; Montero Tavera, V.; Guzmán Maldonado, S.H.; Anaya López, J.L. San Rafael, nueva variedad de frijol pinto de reacción neutral al fotoperiodo para el centro de México. Rev. Mex. De Cienc. Agrícolas 2017, 7, 717–722. [Google Scholar] [CrossRef][Green Version]
- Ríos-Saucedo, C.J.; Ramírez-Valadez, G.; Santana Espinoza, M.; Martínez-Fernández, S.M.; Rosales-Serna, R. Importance of the Natural Incidence of the Fusarium Genus in Food Crops Established in Northern México. In Fusarium—An Overview of the Genus; IntechOpen: London, UK, 2021. [Google Scholar]
- Lutz, M.P.; Feichtinger, G.; Défago, G.; Duffy, B. Mycotoxigenic Fusarium and deoxynivalenol production repress chitinase gene expression in the biocontrol agent Trichoderma atroviride P1. Appl. Environ. Microbiol. 2003, 69, 3077–3084. [Google Scholar] [CrossRef]
- Drakopoulos, D.; Meca, G.; Torrijos, R.; Marty, A.; Kägi, A.; Jenny, E.; Forrer, H.-R.; Si, J.; Vogelgsang, S. Control of Fusarium graminearum in wheat with mustard-based botanicals: From in vitro to in planta. Front. Microbiol. 2020, 11, 1595. [Google Scholar] [CrossRef]
- Shirazi, M.; Abid, M.; Hussain, F.; Abbas, A.; Sitara, U. Antifungal activity of some medicinal plant extracts against soil-borne phytopathogens. Pak. J. Bot. 2020, 52, 679–685. [Google Scholar] [CrossRef]
- Grayer, R.J.; Harborne, J.B. A survey of antifungal compounds from higher plants, 1982–1993. Phytochemistry 1994, 37, 19–42. [Google Scholar] [CrossRef]
- Wangkhem, B.; Rana, M.; Jackson, K. Exploring the control measures of white rust-organic amendments, botanicals, biocontrol agents and chemicals. J. Pharmacogn. Phytochem. 2019, 8, 4413–4419. [Google Scholar]
- Şesan, T.; Enache, E.; Lacomi, B.; Oprea, M.; Oancea, F.; Lacomi, C. Antifungal activity of some plant extracts against Botrytis cinérea Pers. in the blackcurrant crop (Ribes nigrum L.). Acta Sci. Pol. Hortorum Cultus Acta 2015, 14, 29–43. [Google Scholar]
- Melo, P.; Alves, E.; Martins, C.; Anjos Neto, A.; Pinto, K.; Araújo, L.; Vieira, C.; Nascimento, L. Extracts of Caesalpinia ferrea and Trichoderma sp. on the control of Colletotrichum sp. transmission in Sideroxylon obtusifolium seeds. Rev. Bras. De Plantas Med. 2016, 18, 494–501. [Google Scholar] [CrossRef]
- Wang, S.; Zheng, Y.; Xiang, F.; Li, S.; Yang, G. Antifungal activity of Momordica charantia seed extracts toward the pathogenic fungus Fusarium solani L. J. Food Drug Anal. 2016, 24, 881–887. [Google Scholar] [CrossRef]
- Tala, M.; Ansary, M.; Talontsi, F.; Kowa, T.; Islam, M.; Tane, P. Anthraquinones and flavanols isolated from the vegetable herb Rumex abyssinicus inhibit motility of Phytophthora capsici zoospores. S. Afr. J. Bot. 2018, 115, 1–4. [Google Scholar] [CrossRef]
- Chiocchio, I.; Mandrone, M.; Tacchini, M.; Guerrini, A.; Poli, F. Phytochemical profile and in vitro bioactivities of plant-based by-products in view of a potential reuse and valorization. Plants 2023, 12, 795. [Google Scholar] [CrossRef]
- Rico, X.; Gullón, B.; Alonso, J.L.; Yáñez, R. Recuperación de compuestos de alto valor agregado a partir de subproductos del procesamiento de piña, melón, sandía y calabaza: Una visión general. Food Res. Int. 2020, 132, 109086. [Google Scholar] [CrossRef]
- Enciso-Martínez, Y.; Zuñiga-Martínez, B.S.; Ayala-Zavala, J.F.; Domínguez-Avila, J.A.; González-Aguilar, G.A.; Viuda-Martos, M. Agro-Industrial By-Products of Plant Origin: Therapeutic Uses as well as antimicrobial and antioxidant activity. Biomolecules 2024, 14, 762. [Google Scholar] [CrossRef]
- Dzah, C.S.; Duan, Y.; Zhang, H.; Boateng, N.A.S.; Ma, H. Latest developments in polyphenol recovery and purification from plant by-products: A review. Trends Food Sci. Technol. 2020, 99, 375–388. [Google Scholar] [CrossRef]
- Gutiérrez-Grijalva, E.P.; Antunes-Ricardo, M.; Acosta-Estrada, B.A.; Gutiérrez-Uribe, J.A.; Heredia, J.B. Actividad antioxidante celular e inhibición in vitro de la α-glucosidasa, α-amilasa y lipasa pancreática de polifenoles de orégano bajo digestión gastrointestinal simulada. Food Res. Int. 2019, 116, 676–686. [Google Scholar] [CrossRef]
- Reyes-Jurado, F.; Cervantes-Rincón, T.; Bach, H.; López-Malo, A.; Palou, E. Antimicrobial activity of Mexican oregano (Lippia berlandieri), thyme (Thymus vulgaris), and mustard (Brassica nigra) essential oils in gaseous phase. Ind. Crops Prod. 2019, 131, 90–95. [Google Scholar] [CrossRef]
- Frías-Zepeda, M.E.; Rosales-Castro, M. Efecto de las condiciones de extracción sobre la concentración de compuestos fenólicos en residuos de orégano mexicano (Lippia graveolens Kunth). Rev. Chapingo Ser. Cienc. For. Y Del Ambiente 2021, 27, 367–381. [Google Scholar] [CrossRef]
- Villegas-Novoa, C.; Gallegos-Infante, J.A.; González-Laredo, R.F.; García-Carrancá, A.M.; Herrera-Rocha, K.M.; Jacobo-Karam, J.S.; Rocha-Guzmán, N.E. Acetone effects on Buddleja scordioides polyphenol extraction process and assessment of their cellular antioxidant capacity and anti-inflammatory activity. Med. Chem. Res. 2019, 28, 2218–2231. [Google Scholar] [CrossRef]
- Trail, F.; Common, R. Perithecial development by Gibberella zeae: A light microscopy study. Mycologia 2000, 92, 130–138. [Google Scholar] [CrossRef]
- Roncero, M.I.; Hera, C.; Ruiz-Rubio, M.; Maceira, F.I.; Madrid, M.P.; Caracuel, Z.; Calero, F.; Delgado-Jarana, J.; Roldán-Rodrıguez, R.; Martınez-Rocha, A.L.; et al. Fusarium as a model for studying virulence in soilborne plant pathogens. Physiol. Mol. Plant Pathol. 2003, 62, 87–98. [Google Scholar] [CrossRef]
- O’Donnell, K. Molecular phylogeny of the Nectria haematococca-Fusarium solani species complex. Mycologia 2000, 92, 919–938. [Google Scholar] [CrossRef]
- Mentges, M.; Glasenapp, A.; Boenisch, M.; Malz, S.; Henrissat, B.; Frandsen, R.J.; Güldener, U.; Münsterkötter, M.; Bormann, J.; Lebrun, M.H.; et al. Infection cushions of Fusarium graminearum are fungal arsenals for wheat infection. Mol. Plant Pathol. 2020, 21, 1070–1087. [Google Scholar] [CrossRef]
- Soylu, S.; Yigitbas, H.; Soylu, E.; Kurt, S. Antifungal effects of essential oils from oregano and fennel Sclerotinia sclerotiorum. J. Appl. Microbiol. 2007, 103, 1021–1030. [Google Scholar] [CrossRef]
- Daryaei, A.; Jones, E.; Glare, T.; Falloon, R. Nutrient amendments affect Trichoderma atroviride conidium production, germination and bioactivity. Biol. Control 2016, 93, 8–14. [Google Scholar] [CrossRef]
- Chang, Y.; Boukari, W.; Riley, S.S.; Harmon, P.F.; Sarkhosh, A.; Brecht, J.K. In vitro antifungal activity of white thyme, oregano, and savory oils against five monilinia fructicola isolates from the Southeastern United States. Plant Health Prog. 2024, 25, PHP-12. [Google Scholar] [CrossRef]
- Zhang, S.; Zheng, Q.; Xu, B.; Liu, J. Identification of the fungal pathogens of postharvest disease on peach fruits and the control mechanisms of Bacillus subtilis JK-14. Toxins 2019, 11, 322. [Google Scholar] [CrossRef] [PubMed]
- De Almeida, J.M.; Crippa, B.L.; de Souza, V.V.M.A.; Alonso, V.P.P.; Júnior, E.D.M.S.; Picone, C.S.F.; Prata, A.S.; Silva, N.C.C. Antimicrobial action of oregano, thyme, clove, cinnamon and black pepper essential oils free and encapsulated against foodborne pathogens. Food Control 2023, 144, 109356. [Google Scholar] [CrossRef]
- Pilozo, G.; Villavicencio-Vásquez, M.; Chóez-Guaranda, I.; Murillo, D.V.; Pasaguay, C.D.; Reyes, C.T.; Maldonado-Estupiñan, M.; Ruiz-Barzola, O.; León-Tamariz, F.; Manzano, P. Chemical, antioxidant, and antifungal analysis of oregano and thyme essential oils from Ecuador: Effect of thyme against Lasiodiplodia theobromae and its application in banana rot. Heliyon 2024, 10, e31443. [Google Scholar] [CrossRef] [PubMed]
- Li, L.; Zhu, T.; Song, Y.; Feng, L.; Kear, P.J.; Riseh, R.S.; Sitohy, M.; Datla, R.; Ren, M. Salicylic acid fights against Fusarium wilt by inhibiting target of rapamycin signaling pathway in Fusarium oxysporum. J. Adv. Res. 2022, 39, 1–13. [Google Scholar] [CrossRef]
- Cuzick, A.; Urban, M.; Hammond-Kosack, K. Fusarium graminearum gene deletion mutants map1 and tri5 reveal similarities and differences in the pathogenicity requirements to cause disease on Arabidopsis and wheat floral tissue. New Phytol. 2008, 177, 990–1000. [Google Scholar] [CrossRef]
- Bluemke, A.; Falter, C.; Herrfurth, C.; Sode, B.; Bode, R.; Schäfer, W.; Feussner, I.; Voigt, C.A. Secreted fungal effector lipase releases free fatty acids to inhibit innate immunity-related callose formation during wheat head infection. Plant Physiol. 2014, 165, 346–358. [Google Scholar] [CrossRef]
- Brown, N.A.; Urban, M.; Van, D.; Meene, A.M.L.; Hammond-Kosack, K.E. The infection biology of Fusarium graminearum: Defining the pathways of spikelet to spikelet colonisation in wheat ears. Fungal Biol. 2010, 114, 555–571. [Google Scholar] [CrossRef]
- Brown, N.A.; Evans, J.; Mead, A.; Hammond-Kosack, K.E. A spatial temporal analysis of the Fusarium graminearum transcriptome during symptomless and symptomatic wheat infection. Mol. Plant Pathol. 2017, 18, 1295–1312. [Google Scholar] [CrossRef]
- Ghitti, E.; Rolli, E.; Crotti, E.; Borin, S. Flavonoids are intra-and inter-kingdom modulator signals. Microorganisms 2022, 10, 2479. [Google Scholar] [CrossRef]
- Ratnasari, N.; Walters, M.; Tsopmo, A. Antioxidant and lipoxygenase activities of polyphenol extracts from oat brans treated with polysaccharide degrading enzymes. Heliyon 2017, 3, e00351. [Google Scholar] [CrossRef]
- Owczarek, K.; Lewandowska, U. The Impact of Dietary Polyphenols on COX-2 Expression in Colorectal Cancer. Nutr. Cancer 2017, 69, 1105–1118. [Google Scholar] [CrossRef] [PubMed]
- Yeoh, B.S.; Aguilera Olvera, R.; Singh, V.; Xiao, X.; Kennett, M.J.; Joe, B.; Lambert, J.D.; Vijay-Kumar, M. Epigallocatechin-3-Gallate inhibition of myeloperoxidase and its counter-regulation by dietary iron and lipocalin 2 in murine model of gut inflammation. The Am. J. Pathol. 2016, 186, 912–926. [Google Scholar] [CrossRef]
- Yousefian, M.; Shakour, N.; Hosseinzadeh, H.; Hayes, A.W.; Hadizadeh, F.; Karimi, G. The natural phenolic compounds as modulators of NADPH oxidases in hypertension. Phytomedicine 2019, 55, 200–213. [Google Scholar] [CrossRef]
- Liu, L.; Zhang, L.; Ren, L.; Xie, Y. Advances in structures required of polyphenols for xanthine oxidase inhibition. Food Front. 2020, 1, 152–167. [Google Scholar] [CrossRef]
- Rudrapal, M.; Khairnar, S.J.; Khan, J.; Dukhyil, A.B.; Ansari, M.A.; Alomary, M.N.; Alshabrmi, F.M.; Palai, S.; Deb, P.K.; Devi, R. Dietary polyphenols and their role in oxidative stress-induced human diseases: Insights into protective effects, antioxidant potentials and mechanism(s) of action. Front. Pharmacol. 2022, 13, 806470. [Google Scholar] [CrossRef] [PubMed]
- Chen, L.; Wu, Q.; He, T.; Lan, J.; Ding, L.; Liu, T.; Wu, Q.; Pan, Y.; Chen, T. Transcriptomic and metabolomic changes triggered by Fusarium solani in common bean (Phaseolus vulgaris L.). Genes 2020, 11, 177. [Google Scholar] [CrossRef]
- Robatzek, S. Endocytosis: At the crossroads of pattern recognition immune receptors and pathogen effectors. In Applied Plant Cell Biology; Springer: Berlin/Heidelberg, Germany, 2014; pp. 273–297. [Google Scholar]
- Xue, R.; Wu, J.; Zhu, Z.; Wang, L.; Wang, X.; Wang, S.; Blair, M.W. Differentially expressed genes in resistant and susceptible common bean (Phaseolus vulgaris L.) genotypes in response to Fusarium oxysporum f. sp. phaseoli. PLoS ONE 2015, 10, e0127698. [Google Scholar] [CrossRef]

| Compound | Stem Extract (%) | Leaf Extract (%) |
|---|---|---|
| Naringenin | 27.0 | 22.8 |
| Taxofolin | 21.1 | 17.3 |
| Caffeic acid | 10.6 | 14.5 |
| Eriodityol | 18.1 | 14.3 |
| Acacetin | 0.7 | 8.5 |
| Luteolin | 8.6 | 5.1 |
| Quercetin 3-O-Glucoside | 2.1 | 3.2 |
| Coumaric acid | 3.8 | 2.1 |
| 2-hydroxybenzoic acid | 1.7 | 1.5 |
| Apigenin | 1.5 | 1.2 |
| Phrolidin | 0.8 | 1.1 |
| Quercetin | 0.7 | 0.7 |
| Protocatechuic acid | 0.9 | 0.5 |
| Neohesperidin | 0.7 | 0.5 |
| Rutosidum | 0.2 | 0.4 |
| Quinic acid | 0.3 | 0.3 |
| 4-hydroxybenzoix acid | 0.5 | 0.3 |
| Conidia Treatment | Fusarium spp. | Beans (n) | Sprouted | Infected | Infection Level | ||
|---|---|---|---|---|---|---|---|
| Mild | Moderate | Severe | |||||
| SFN | Without conidia | 12 (100%) | 10 (83.3%) | 0 (0%) | 0 (0%) | 0 (0%) | 0 (0%) |
| SFC | F. graminearum | 12 (100%) | 6 (50%) | 12 (100%) | 1 (8.3%) | 3 (25%) | 8 (66.6%) |
| F. solani | 12 (100%) | 9 (75%) | 5 (41.6%) | 1 (8.3%) | 2 (16.6%) | 2 (16.6%) | |
| F. oxysporum | 12 (100%) | 5 (41.6%) | 12 (100%) | 8 (66.6%) | 2 (16.6%) | 2 (16.6%) | |
| SFH | F. graminearum | 12 (100%) | 3 (25%) | 9 (75%) | 2 (16.6%) | 4 (33.3%) | 3 (25%) |
| F. solani | 12 (100%) | 2 (16.6%) | 12 (100%) | 2 (16.6%) | 2 (16.6%) | 8 (66.6%) | |
| F. oxysporum | 12 (100%) | 3 (25%) | 10 (83.3%) | 0 (0%) | 0 (0%) | 10 (83.3%) | |
| SFTA | F. graminearum | 12 (100%) | 4 (36.3%) | 11 (91.6%) | 3 (27.2%) | 2 (16.6%) | 6 (54.5%) |
| F. solani | 12 (100%) | 1 (8.3%) | 12 (100%) | 0 (0%) | 1 (8.3%) | 11 (91.6%) | |
| F. oxysporum | 12 (100%) | 0 (0%) | 12 (100%) | 4 (33.3%) | 0 (0%) | 8 (66.6%) | |
| SFTEB | F. graminearum | 12 (100%) | 5 (41.6%) | 12 (100%) | 4 (33.3%) | 3 (25%) | 5 (41.6%) |
| F. solani | 12 (100%) | 8 (66.6%) | 4 (33.3%) | 2 (16.6%) | 0 (0%) | 2 (16.6%) | |
| F. oxysporum | 12 (100%) | 6 (50%) | 8 (66.6%) | 1 (8.3%) | 0 (0%) | 5 (41.6%) | |
Disclaimer/Publisher’s Note: The statements, opinions and data contained in all publications are solely those of the individual author(s) and contributor(s) and not of MDPI and/or the editor(s). MDPI and/or the editor(s) disclaim responsibility for any injury to people or property resulting from any ideas, methods, instructions or products referred to in the content. |
© 2024 by the authors. Licensee MDPI, Basel, Switzerland. This article is an open access article distributed under the terms and conditions of the Creative Commons Attribution (CC BY) license (https://creativecommons.org/licenses/by/4.0/).
Share and Cite
Cabral-Miramontes, J.P.; Martínez-Rocha, A.L.; Rosales-Castro, M.; Lopez-Rodriguez, A.; Meneses-Morales, I.; Del Campo-Quinteros, E.; Herrera-Ocelotl, K.K.; Gandara-Moreno, G.; Velázquez-Huizar, S.J.; Ibarra-Sánchez, L.; et al. Antifungal Activity of Mexican Oregano (Lippia graveolens Kunth) Extracts from Industrial Waste Residues on Fusarium spp. in Bean Seeds (Phaseolus vulgaris L.). Agriculture 2024, 14, 1975. https://doi.org/10.3390/agriculture14111975
Cabral-Miramontes JP, Martínez-Rocha AL, Rosales-Castro M, Lopez-Rodriguez A, Meneses-Morales I, Del Campo-Quinteros E, Herrera-Ocelotl KK, Gandara-Moreno G, Velázquez-Huizar SJ, Ibarra-Sánchez L, et al. Antifungal Activity of Mexican Oregano (Lippia graveolens Kunth) Extracts from Industrial Waste Residues on Fusarium spp. in Bean Seeds (Phaseolus vulgaris L.). Agriculture. 2024; 14(11):1975. https://doi.org/10.3390/agriculture14111975
Chicago/Turabian StyleCabral-Miramontes, Juan Pablo, Ana Lilia Martínez-Rocha, Martha Rosales-Castro, Angelica Lopez-Rodriguez, Iván Meneses-Morales, Esmeralda Del Campo-Quinteros, Karla Karina Herrera-Ocelotl, Guillermo Gandara-Moreno, Sandra Jocelyn Velázquez-Huizar, Leobardo Ibarra-Sánchez, and et al. 2024. "Antifungal Activity of Mexican Oregano (Lippia graveolens Kunth) Extracts from Industrial Waste Residues on Fusarium spp. in Bean Seeds (Phaseolus vulgaris L.)" Agriculture 14, no. 11: 1975. https://doi.org/10.3390/agriculture14111975
APA StyleCabral-Miramontes, J. P., Martínez-Rocha, A. L., Rosales-Castro, M., Lopez-Rodriguez, A., Meneses-Morales, I., Del Campo-Quinteros, E., Herrera-Ocelotl, K. K., Gandara-Moreno, G., Velázquez-Huizar, S. J., Ibarra-Sánchez, L., & Ruiz-Baca, E. (2024). Antifungal Activity of Mexican Oregano (Lippia graveolens Kunth) Extracts from Industrial Waste Residues on Fusarium spp. in Bean Seeds (Phaseolus vulgaris L.). Agriculture, 14(11), 1975. https://doi.org/10.3390/agriculture14111975

